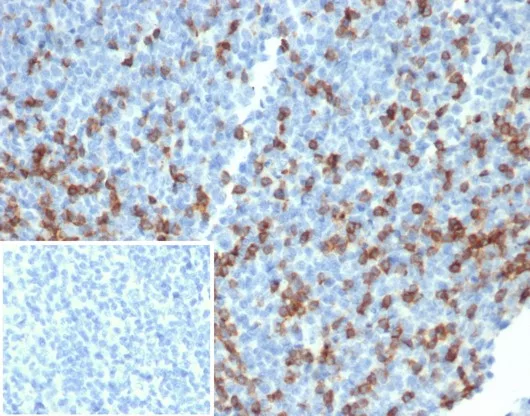

Formalin-fixed, paraffin-embedded human tonsil stained with PD1 (CD279) Recombinant Rabbit Monoclonal Antibody (PDCD1/4231R). Inset: PBS instead of primary antibody; secondary only negative control.
PDCD-1 (programmed cell death-1 protein), also designated CD279, is a type I transmembrane receptor and a member of the immunoglobin gene superfamily. It is expressed on activated T-cells, B-cells, and myeloid cells. Anti-PDCD-1 is a marker of angioimmunoblastic lymphoma and suggests a unique cell of origin for this neoplasm. Unlike CD10 and BCL6, PDCD-1 is expressed by few B-cells, so anti-PDCD-1 may be a more specific and useful diagnostic marker in angioimmunoblastic lymphoma. In addition, PDCD-1 expression provides evidence that angioimmunoblastic lymphoma is a neoplasm derived from germinal center-associated T-cells.
There are no reviews yet.